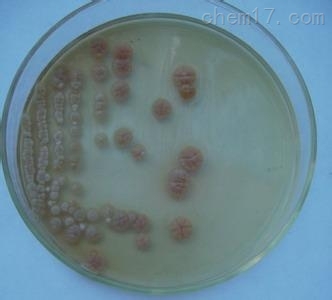

在浩瀚的自然界中,存在着一类微小却强大的生物群体——科研菌株。它们虽不起眼,却在生命科学研究、医药开发、环境保护乃至食品工业等多个领域发挥着不可替代的作用。这些经过精心筛选与培养的微生物,如同微观世界的科研先锋,带领着人类深入探索生命的奥秘。
科研菌株之所以重要,首先在于它们作为模式生物的价值。科学家们常常利用特定的菌株来研究生命的基本过程,如遗传信息的传递、代谢途径的调控等。以大肠杆菌为例,这种常见的肠道菌群成员,因其遗传背景清晰、生长迅速且易于操作,成为了分子生物学研究中的经典模式生物。通过对其进行基因改造,科学家们能够揭示生命活动的普遍规律,为更复杂的生物系统研究奠定基础。
在医药领域,它的应用更是广泛而深远。许多抗生素和疫苗的研发,都离不开对特定菌株的研究。比如,青霉素的发现就是源于对青霉菌的深入研究,这一发现改变了人类对抗细菌感染的方式。而疫苗的研发过程中,科研人员也常利用减毒或灭活的病原体菌株作为免疫原,激发人体产生免疫力,从而预防疾病的发生。此外,随着基因工程技术的进步,科研人员还能够利用改造后的菌株生产重组蛋白药物,如胰岛素、干扰素等,为治疗多种疾病提供了有效手段。
除了直接服务于医药研发,还在环境保护方面展现出巨大潜力。某些微生物具有降解污染物的能力,通过筛选和培养这类菌株,科学家们能够开发出高效的生物修复技术,用于处理工业废水、土壤污染等问题。这不仅减少了化学处理方法可能带来的二次污染,还实现了环境友好型的污染治理。例如,利用特定菌株降解石油烃类物质,已经在石油污染场地的修复中得到了实际应用。
在食品工业中,同样扮演着重要角色。发酵是食品加工中的关键环节,而发酵过程中使用的菌株直接影响到食品的品质和安全性。科研人员通过对传统发酵菌株的改良和新菌株的开发,不断提高食品的营养价值和口感风味。比如,酸奶、泡菜等发酵食品的制作,就离不开对乳酸菌等有益菌株的研究和应用。同时,还在新型食品原料的开发上发挥着作用,如利用微生物发酵生产植物蛋白、功能性多糖等,为食品工业的创新提供了更多可能。
值得一提的是,随着合成生物学的发展,它的应用前景愈发广阔。科学家们通过设计和构建人工基因线路,使微生物能够执行原本不属于它们的生物功能。这种“定制化”的菌株不仅可用于生产稀有化合物、生物燃料等,还能在疾病诊断、环境监测等领域发挥作用。比如,通过改造大肠杆菌使其能够检测水中的重金属离子浓度,为环境监测提供了新的工具。
科研菌株的使用也伴随着一定的风险和挑战。一方面,基因改造可能带来未知的生态风险,因此需要严格评估和监管;另一方面,如何确保改造后的菌株在实际应用中的安全性和稳定性,也是科研人员需要解决的关键问题。此外,随着研究的深入,科学家们还面临着如何更有效地挖掘和利用自然中存在的微生物资源的问题。
科研菌株作为微观世界的科研先锋,正以其魅力和无限的潜能,推动着人类对生命奥秘的探索进程。在未来的研究中,我们期待着更多关于它的创新性应用和技术突破的出现。